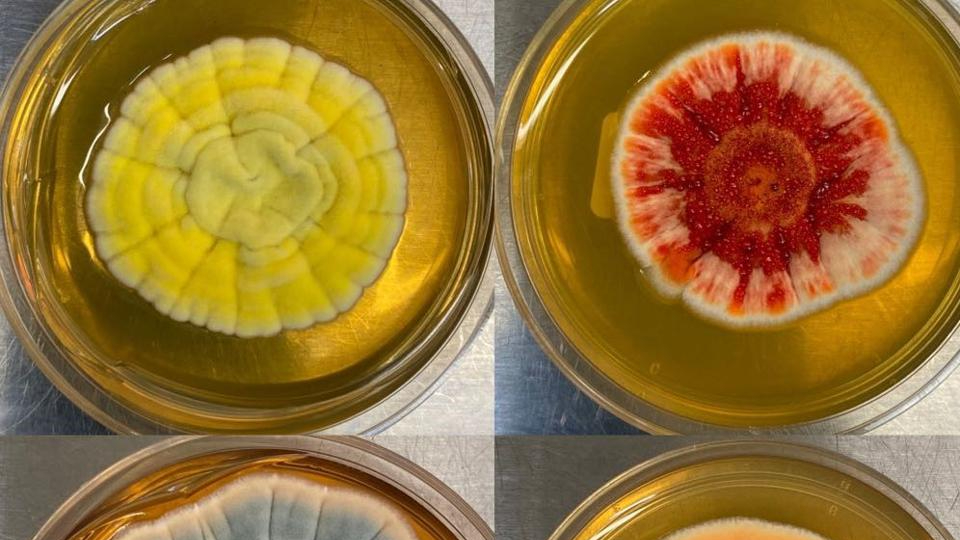
Forbes tweet media

Sabitlenmiş Tweet
Flygerian
8.3K posts

Flygerian
@Slickydee
Believer with a knack for humanitarianism. Greater is Christ in you, the hope of Glory, than he that is in the world. (1John 4:4; Col.1:27) #YEARN
ÜT: 2.820206,101.876017 Katılım Ağustos 2009
1.4K Takip Edilen742 Takipçiler
Flygerian retweetledi

"We are here this afternoon to change the course of history."
now.CBN.com/KtN850BsOdG
English
Flygerian retweetledi

FEDERAL GOVERNMENT LAUNCHES N75BN MSME SURVIVAL FUND FOR NIGERIAN MSME's ON SEPTEMBER 21:
N75bn Survival Fund For Nigerian MSMEs Is 100% Grant, NOT LOAN! Please Share Widely.
survivalfund.ng
Registration Begins September 21st, 2020 On The Website.

English
Flygerian retweetledi

Now this changes *everything*
@krakenfx has just been granted a banking license in Wyoming to open the world's first fully regulated crypto bank.
Bill payments, custody, salary payments seamlessly available in fiat and crypto.
beincrypto.com/breaking-krake…
English
Flygerian retweetledi

Good afternoon #AbujaTwitterCommunity
Please a client urgently needs a "pay and pack in" semi detached duplex at Wuye or Life Camp
Budget is 60m
If you have kindly DM me.
@potam0413 @am_dknowl @Uncle2Triplets @Kestim_ @
English
Flygerian retweetledi

This biotech startup just raised $47 million to make drugs from fungi: on.forbes.com/6016GQOka
English
Flygerian retweetledi
Flygerian retweetledi
Flygerian retweetledi

BREAKING: Nigeria’s SEC classifies cryptocurrencies as securities in landmark regulatory document businessday.ng/lead-story/art…

English
Flygerian retweetledi
Flygerian retweetledi
Flygerian retweetledi
Flygerian retweetledi
Flygerian retweetledi

@Slickydee @volqx Wow! It’s my pleasure. Happy we share same day. May God grant your heart desires 🙏🏻
English

It's been a turbulent year full of lots of lows, feelings of delayed goals, battled health challenges, yet I'm still here blessed by the Father's grace to brace yet another birthday. One thing I learnt this year indeed from my meeting with @Mazigburugburu1 always stay humble...
English








